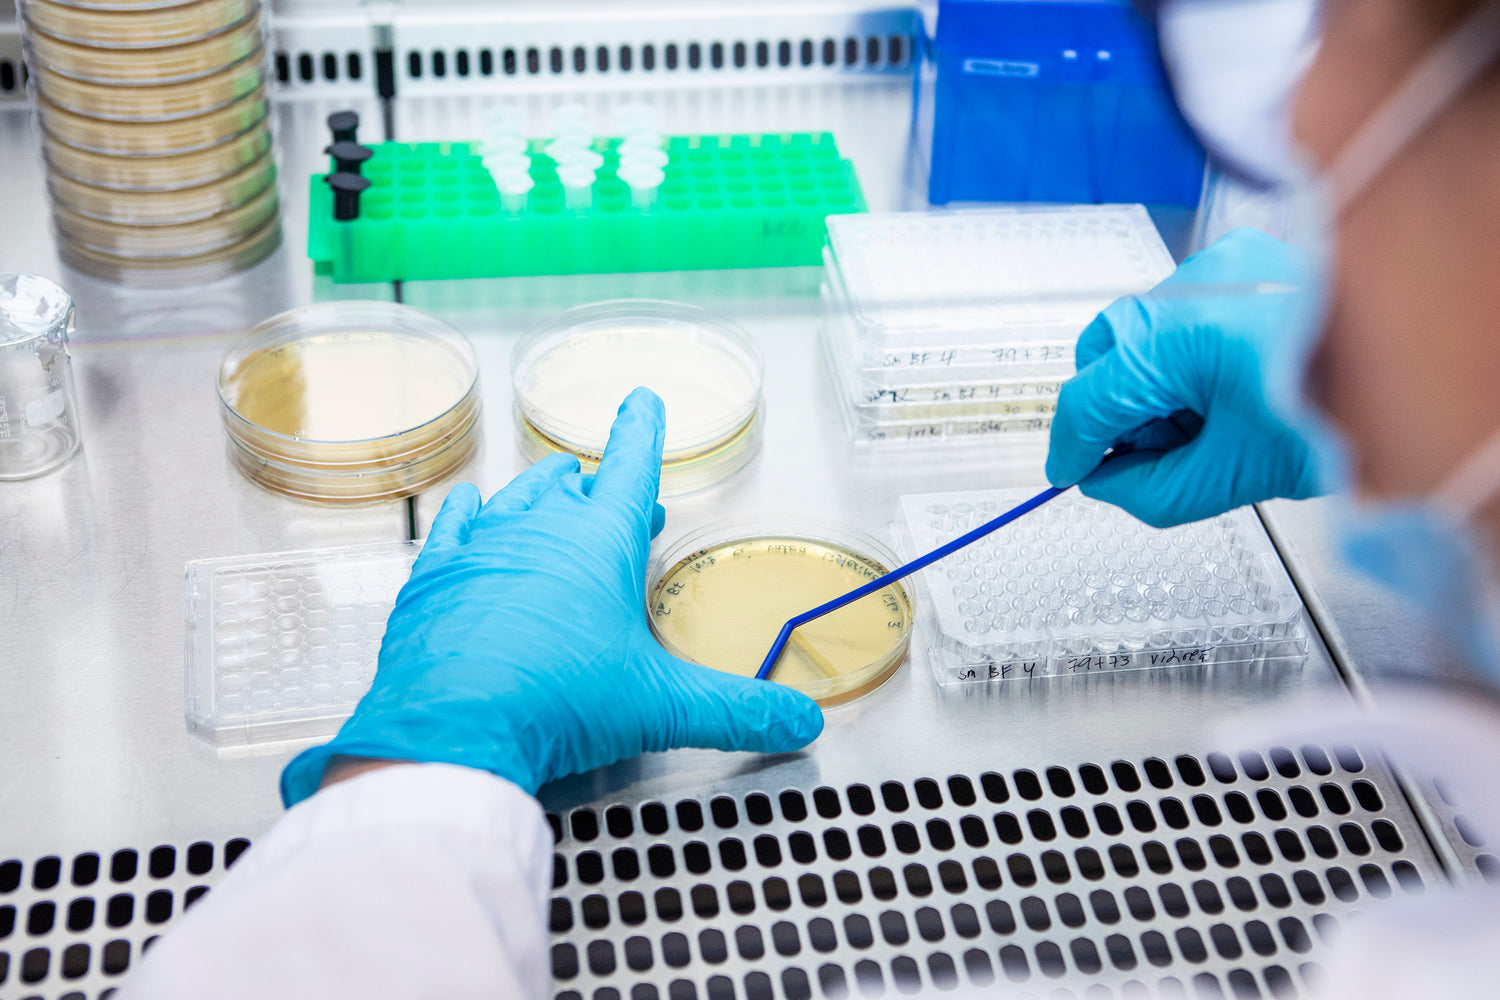
Kaksi vuotta suun terveyden edistämistä

Terve suu on hyvinvoinnin perusta. Siksi kehitimme Lumoral-hoidon.
Vuonna 2016 alkoi laaja tutkimus-ja tuotekehitysprojekti, jonka pohjalta kesäkuussa 2020 toimme markkinoille suunterveyttä edistävän Lumoral-hoidon. Panoksensa tälle suun terveyden omahoidon mullistavalle innovaatiolle ovat antaneet niin hammaslääkärit, lääkärit ja kemistit kuin puolijohde-, bakteeri- ja geenitutkijat.
Kehitimme Lumoral-menetelmän, koska uskomme, että terve suu on hyvän elämän ja hyvinvoinnin perusta. Haluamme, että siitä saa nauttia ihan jokainen. Bakteerien aiheuttamat suun sairaudet ovat merkittävä kansanterveydellinen ja kansantaloudellinen ongelma. Ne ovat kuitenkin ennaltaehkäistävissä, ja kotona tapahtuvalla hoidolla on tässä valtava merkitys.
Vuosien mittaan olemme jatkaneet tutkimus- ja kehitystyötä yhdessä yliopistosairaaloiden, hammaslääkäreiden ja arvostettujen hammaslääketieteen professoreiden kanssa. Tällä hetkellä Lumoral on mukana kolmessa kliinisessä tutkimuksessa Helsingissä. Suomen laajin parodontiitin hoitoa tarkasteleva tutkimus on alkanut Metropolia-ammattikorkeakoulussa. Se kartoittaa Lumoral-hoidon hyötyjä parodontiitin hoidossa verrattuna samankokoiseen kontrolliryhmään. HUS:in Huuli-ja suulakihalkiokeskuksessa arvioidaan Lumoral-hoitoa huuli-ja suulakihalkiopotilaiden suuhygienian tehostamisessa. Viimeisin tutkimus käynnistyi toukokuussa HUSin suu- ja leukakirurgian yksikössä. Siinä tarkastellaan Lumoral-hoidon potentiaalia hammasimplanttien aiheuttamien tulehdusten ennaltaehkäisyssä.
Lisää tutkimuksia on myös alkamassa tämän vuoden puolella. Ne liittyvät parodontiitin hoitoon, iäkkäiden suuhygienian hoitoon, ja suun punajäkälän (oral lichen planus) hoitoon. Jo toteutuneita tutkimustuloksiamme on julkaistu vuoden aikana kansainvälisesti tunnetuissa tiedejulkaisuissa, joihin voit tutustua lisää Lumoralin tiede-osiossa.
Lumoral soveltuu bakteerien aiheuttamien suun sairauksien hoitoon.
Vuosien työn tuloksena yksi tärkeistä saavutetuista etapeista on Lumoral-laitteelle myönnetty Euroopan laajuinen CE IIa -luokan hyväksyntä bakteerien aiheuttamien suun sairauksien hoitoon. Tuote on täyttänyt European Medical Directiven vaatimukset parodontiitin ja karieksen hoitoon soveltuvana lääkinnällisenä laitteena.
Hampaiden mekaaninen puhdistus on omahoidon kulmakivi, mutta jäännösplakin hallintaan ei ole aikaisemmin löydetty ratkaisua. Tutkimukset ovat osoittaneet Lumoral-laitteen ennennäkemättömän antibakteerisen tehon biofilmiä (hammasplakkia) vastaan. Harjauksen jälkeen jäävä jäännösplakki voidaan inaktivoida kohdennetusti ja tehokkaasti. Myös uuden plakin muodostuminen hidastuu.
Pitkäaikaiskäyttöön soveltuva patentoituun kaksoisvaloon perustuva antibakteerinen vaikutus kohdentuu paikallisesti ainoastaan plakkiin eikä vaikuta suun normaaliflooraan. Hoidolle ei muodostu resistenssiä.
”Jos on parodontiitille altistavia tekijöitä kannattaa harkita Lumoralin käyttöönottoa. Sen edut ovat merkittävät ja tämä on menetelmä, jonka terveyttä edistävä vaikutus on kiistaton.”– Pirta Liljekvist, Hammaslääkäri
Tutustu lisää Lumoral-hoitoon Miksi Lumoral-osiossa.
Tyytyväisten käyttäjien ja ammattilaisten suosima
Toteutimme tammikuussa 2022 asiakaskyselyn verkkokauppa-asiakkaillemme Suomessa. Yli puolet kaikista vastaajista antoi Lumoral-hoidolle arvosanan 9 tai 10 (asteikolla 1–10) ja valtaosa suosittelisi tuotetta myös ystävälleen. Suun ja hampaiden puhtauden kokemus, värjäytymien vähentyminen, ienterveyden kohentuminen ja myönteinen palaute omalta hammaslääkäriltä nousivat vastauksissa käyttäjille tärkeinä hyötyinä.
Useat hammaslääkäri- ja suuhygienistiklinikat suosittelevat Lumoralia asiakkailleen. Lumoral-menetelmään perehtyneet klinikat tarjoavat asiantuntevaa palvelua ja neuvovat Lumoralin käytössä. Parodontologit ja suukirurgit ovat raportoineet ennennäkemätöntä kehitystä ienterveydessä potilaillaan, jotka käyttävät Lumoralia.